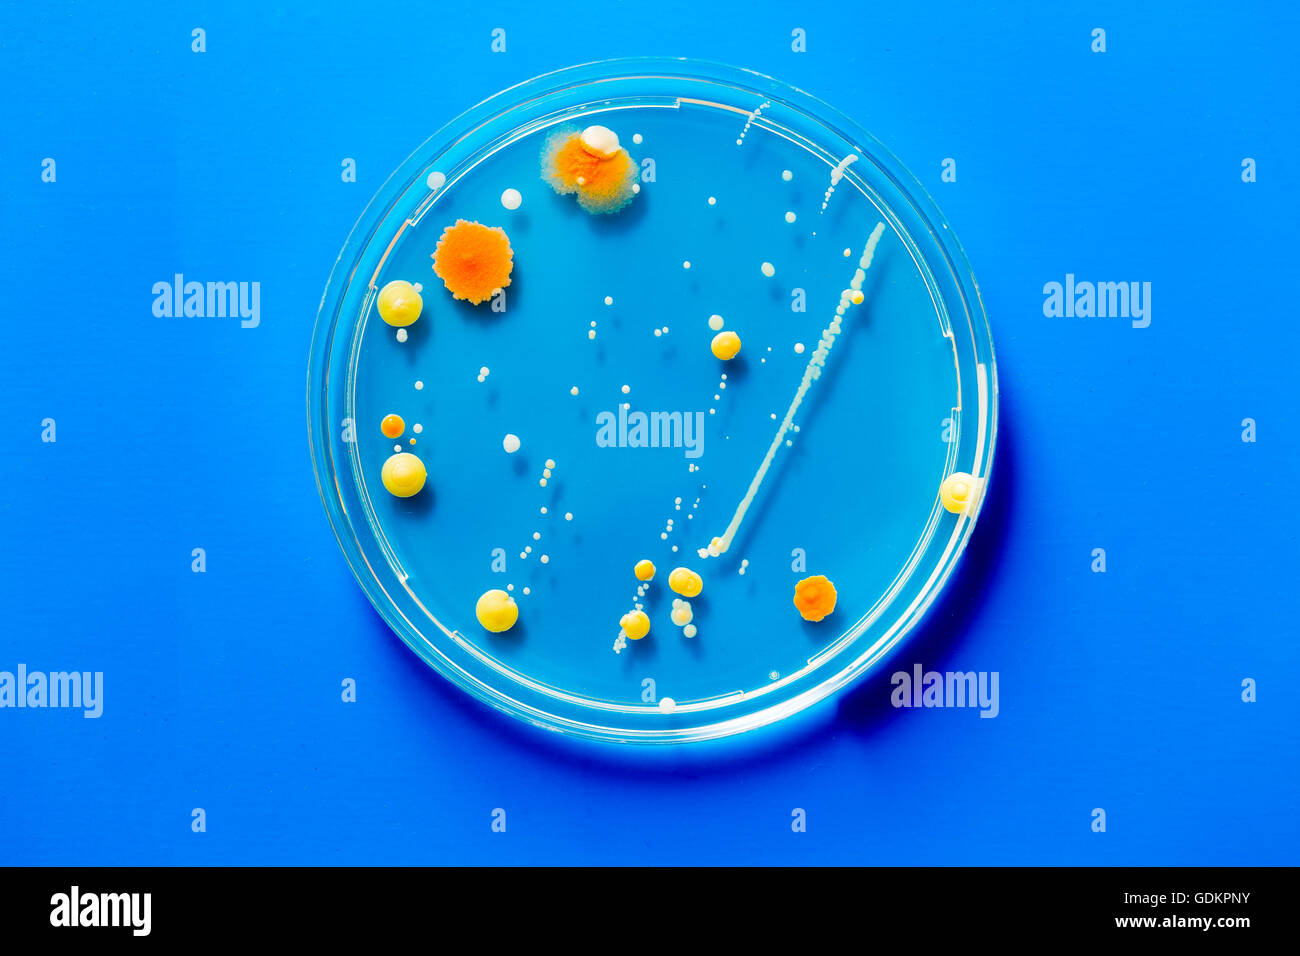
Microbe Banque de photographies et d’images

Il faut donc être extrêmement vigilant lorsque l’on utilise des boites de conserve ou des produits emballés sous vide. Le législateur est clair à ce sujet, dans le milieu de l’alimentation nous n’avons pas le droit d’acheter ou de vendre et encore moins d’utiliser des boites de conserve qui ne sont pas intègres (sertissage.. Solution Microbe sorti d’une boite 12 lettres : Découvrez la solution de cette définition : PANDORAVIRUS. Découvrez d’autres solutions : Mots fléchés. Cette entrée a été publiée dans Mots croisés le 22 juin 2023 par Benjamin Devillers . ← Sont du tertiaire 8 lettres mots croisés Elle ouvre la voie à un transfert de propriété.
Les microbes expliqués aux enfants rts.ch Les microbes

LES MICROBES OU BACTERIES EXPLIQUES AUX ENFANTS

Microbiome définition et explications

My life, my world, my Microbe La boîte à pharmacie
Microbe Banque de photographies et d’images à haute résolution Alamy

Illustration Vectorielle De Boîte De Pétri Avec Des Microbes Vecteur Premium

Boîte De Pétri Avec Des Microbes Illustration Stock Illustration du virus, concept 79802903

Les microbes sont ils tous dangereux ? BIO CONSEIL

Microbes comment et pourquoi se multiplientils ? Nets

Microbe, virus, bactérie quelle différence
Le microbe sous toutes ses formes rts.ch Les microbes

La Différence Entre Un Virus Et Une Bactérie Diverses Différences

Fin Vers Le Haut De La Boîte De Pétri Avec La Colonie De Microbe Photo stock Image du

Reconnaître et encadrer la microbiologie Agence SciencePresse

Les microbes, toujours plus résistants aux traitements Ça s’explique RadioCanada Première

Les microbes 5e Cours SVT Kartable

Art et Sciences 7 Microbial Art et art bactérien des œuvres d’art dans des boites de Pétri

Pile de pétri avec les cultures de les champignons et les microbes. Une boîte

Empreinte de la main Nous savons tous que notre corps abrite d’innombrables millions de

Les microbes de plus en boîte de Pétri Photo Stock Alamy
La boîte aux lettres. Vol. 4 – No 1 Printemps 2001. Années de parution. Comment désinfecter les petits pots et les toilettes ? Par Julio C. Soto, Institut national de santé publique du Québec. Les installations des centres de la petite enfance et les garderies doivent disposer d’une toilette et d’un lavabo par groupe de quinze.. MICROBE SORTI D’UNE BOITE EN 12 LETTRES – 1 RÉPONSE : * Les résultats sont triés par ordre de pertinence avec le nombre de lettres entre parenthèses. Cliquez sur un mot pour découvrir sa définition . MICROBE SORTI D’UNE BOITE EN 15 LETTRES – 1 RÉPONSE : *




